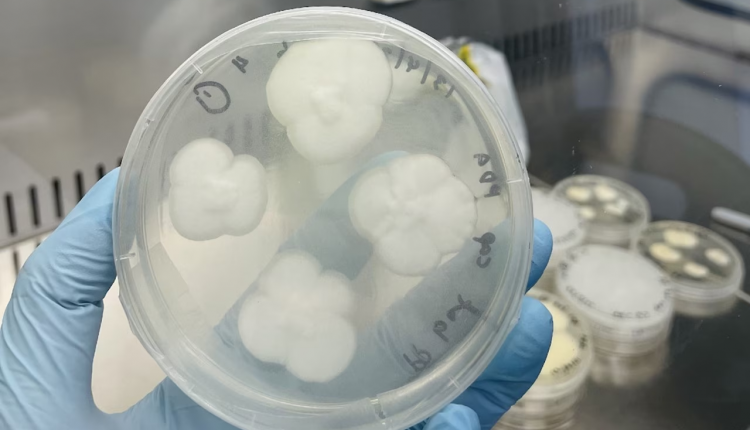
Engyodontium album.

Fungi Makes Meal of Hard to Recycle Plastic
Fungi Makes Meal of Hard to Recycle Plastic
Polypropylene, a hard to recycle plastic, has successfully been biodegraded by two strains of fungi in a new experiment led by researchers at the University of Sydney.
Polypropylene has long been recycling’s head scratching riddle. A common plastic used for a wide variety of products from packaging and toys to furnishing and fashion, it accounts for roughly 28 percent of the world’s plastic waste, but only 1 percent of it is recycled.
Now, thanks to the efforts of researchers at the University of Sydney, the recalcitrant polymer may have met its match. Published today in npj: Materials Degradation, two common strains of fungi were used to successfully biodegrade polypropylene in a laboratory experiment.
Typically found in soil and plants, Aspergillus terreus and Engyodontium album were able to break down polypropylene after it had been pre-treated with either UV light or heat, reducing the plastic by 21 percent over 30 days of incubation, and by 25-27 percent over 90 days.
“Polypropylene is a common plastic used to make a huge variety of everyday products like food containers, coat hangers and cling film, but it only has a recycling rate of only one percent, meaning it is overrepresented in plastic waste and pollution globally,” said the study’s lead author from the University of Sydney’s School of Chemical and Biomolecular Engineering, PhD student Amira Farzana Samat.
The researchers hope their method could one day reduce the vast amount of plastic polluting the environment and lead to a greater understanding of how plastic pollution might biodegrade naturally under certain conditions.
“Plastic pollution is by far one of the biggest waste issues of our time. The vast majority of it isn’t adequately recycled, which means it often ends up in our oceans, rivers and in landfill. It’s been estimated that 109 million tonnes of plastic pollution have accumulated in the world’s rivers and 30 million tonnes now sit in the world’s oceans – with sources estimating this will soon surpass the total mass of fish,” said Mrs Samat.
The researchers say polypropylene is so infrequently recycled because of its short life as a packaging material and because it often becomes contaminated by other materials and plastics, necessitating new recycling methods that have minimal environmental impact.
Mrs Samat’s PhD supervisor, Professor Ali Abbas from the School of Chemical and Molecular Engineering and Chief Circular Engineer at Circular Australia said: “Despite the massive scale of plastic production and consumption, there has been very little attention paid to plastics degradation under environmental conditions, and our understanding of how plastics can be degraded is limited.”
“One big question our result has raised is – what are the naturally occurring conditions which can fast track the degradation of plastics? We seek to further explore the role of biological processes offered by fungi and other microorganisms.”
Professor Dee Carter, an expert in mycology (the study of fungi) in the School of Life and Environmental Sciences and co-author of the study said: “Fungi are incredibly versatile and are known to be able to break down pretty much all substrates. This superpower is due to their production of powerful enzymes, which are excreted and used to break down substrates into simpler molecules that the fungal cells can then absorb.”
“Often, these fungi have evolved to break down woody materials, but this ability can be repurposed to attack other substrates. This is why we find fungi growing on all sorts of man-made materials like carpets, painted furniture, tile grout, shower curtains, upholstery and even car headlights.
“Recent studies suggest some fungi may even degrade some of the ‘forever chemicals’ like PFAS, but the process is slow and not yet well understood. There is also evidence that the amount of plastic accumulated in the ocean is less than what might be expected based on production and disposal levels, and there is speculation that some of this ‘missing’ plastic may have been degraded by marine fungi.”
Polypropylene in various forms was initially treated with one of three separate methods: ultraviolet light, heat, and Fenton’s reagent – an acidic solution of hydrogen peroxide and ferrous iron often used to oxidise contaminants.
In a petri dish, the fungi were applied separately as single cultures to treated polypropylene. The validity of the biodeterioration was then confirmed through microscopy techniques. While the research didn’t evaluate how the plastic was degraded by the fungi or whether it was metabolised, the researchers hope to conduct further research to determine the type of bio-chemical processes taking place.
Professor Abbas believes the low rate of plastics recycling globally presents a “massive plastics circularity gap”: “We need to support the development of disruptive recycling technologies that improve the circularity of plastics, especially those technologies that are driven by biological processes like in our study. It is important to note that our study did not yet carry out any optimisation of the experimental conditions, so there is plenty of room to further reduce this degradation time.”
The researchers will now explore enhancing the overall efficiency in degrading polypropylene before seeking investment to scale the technology and develop a small-scale pilot prototype for commercialisation.
Since completing the study, the team has isolated other microorganisms from the marine environment and used a similar process to degrade marine plastic waste, with preliminary results showing even higher degradation.
Ms Samat said: “We are quite excited about this and have started looking at different ways to improve the degradation process using these microorganisms.

https://www.sydney.edu.au/
#modernplasticsindia #plasticmagazine #indianmagazine #indianplasticmagazine #modernplasticsaward #ginujoseph #modernplastic #plasticindia #plasticnews #plasticrecycling #modernplasticsglobalnetwork #modernglobalnetwok #modernplasticsaward2023 #PlasticIndustry #sydneyedu